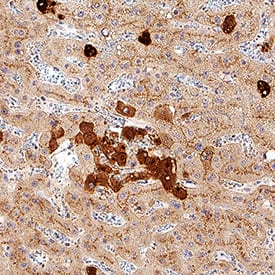
Clusterin antibody in Human Liver by Immunohistochemistry (IHC-P).

Human Clusterin Antibody
R&D Systems, part of Bio-Techne | Catalog # MAB29372


Key Product Details
Species Reactivity
Applications
Label
Antibody Source
Product Specifications
Immunogen
Asp23-Arg227 (beta) & Ser228-Glu449 (alpha)
Accession # NP_001822
Specificity
Clonality
Host
Isotype
Scientific Data Images for Human Clusterin Antibody
Clusterin in Mouse Spleen.
Clusterin was detected in immersion fixed frozen sections of mouse spleen using Mouse Anti-Human Clusterin Monoclonal Antibody (Catalog # MAB29372) at 5 µg/mL for 1 hour at room temperature followed by incubation with the Anti-Mouse IgG VisUCyte™ HRP Polymer Antibody (Catalog # VC001). Tissue was stained using DAB (brown) and counterstained with hematoxylin (blue). Specific staining was localized to cytoplasm. View our protocol for IHC Staining with VisUCyte HRP Polymer Detection Reagents.Clusterin in Human Liver.
Clusterin was detected in immersion fixed paraffin-embedded sections of human liver using Mouse Anti-Human Clusterin Monoclonal Antibody (Catalog # MAB29372) at 1 µg/mL for 1 hour at room temperature followed by incubation with the Anti-Mouse IgG VisUCyte™ HRP Polymer Antibody (Catalog # VC001). Tissue was stained using DAB (brown) and counterstained with hematoxylin (blue). Specific staining was localized to plasma membrane and cytoplasm. View our protocol for IHC Staining with VisUCyte HRP Polymer Detection Reagents.Applications for Human Clusterin Antibody
Immunohistochemistry
Sample: Immersion fixed frozen sections of mouse spleen and immersion fixed paraffin-embedded sections of human liver
Human Clusterin Sandwich Immunoassay
Formulation, Preparation, and Storage
Purification
Reconstitution
Formulation
Shipping
Stability & Storage
- 12 months from date of receipt, -20 to -70 °C as supplied.
- 1 month, 2 to 8 °C under sterile conditions after reconstitution.
- 6 months, -20 to -70 °C under sterile conditions after reconstitution.
Background: Clusterin
Clusterin, also known as Apolipoprotein J, Sulfated Glycoprotein 2 (SGP-2), TRPM-2, and SP-40,40, is a secreted multifunctional protein that was named for its ability to induce cellular clustering. It binds a wide range of molecules and may function as a chaperone of misfolded extracellular proteins. It also participates in the control of cell proliferation, apoptosis, and carcinogenesis (1, 2). Clusterin is predominantly expressed in adult testis, ovary, adrenal gland, liver, heart, and brain and in many epithelial tissues during embryonic development (3). Human Clusterin is synthesized as a precursor that contains two coiled coil domains, three nuclear localization signals (NLS), and one heparin binding domain (4 - 6). Intracellular cleavages of the precursor remove the signal peptide and generate comparably sized alpha and beta chains which are secreted as an 80 kDa N-glycosylated disulfide-linked heterodimer (7, 8). Mature human Clusterin shares 77% amino acid sequence identity with mouse and rat Clusterin. High μg/mL concentrations of Clusterin circulate predominantly as a component of high density lipoprotein particles, and these are internalized and degraded through interactions with LRP-2/Megalin (9, 10). In human, an alternately spliced 50 kDa isoform of Clusterin (nCLU) lacks the signal peptide and remains intracellular (5, 11). This molecule is neither glycosylated nor cleaved into alpha and beta chains (11). In the cytoplasm, nCLU destabilizes the actin cytoskeleton and inhibits NF kappaB activation (12, 13). Cellular exposure to ionizing radiation promotes the translocation of nCLU to the nucleus where it interacts with Ku70 and promotes apoptosis (5, 11). This function contrasts with the cytoprotective effect of secreted Clusterin (14). During colon cancer tumor progression there is a downregulation of the intracellular form and an upregulation of the glycosylated secreted form (11).
References
- Carver, J.A. et al. (2003) IUBMB Life 55:661.
- Shannan, B. et al. (2006) Cell Death Differ. 13:12.
- French, L.E. et al. (1993) J. Cell Biol. 122:1119.
- Kirszbaum, L. et al. (1989) EMBO J. 8:711.
- Leskov, K.S. et al. (2003) J. Biol. Chem. 278:11590.
- Pankhurst, G.J. et al. (1998) Biochemistry 37:4823.
- Burkey, B.F. et al. (1991) J. Lipid. Res. 32:1039.
- de Silva, H.V. et al. (1990) J. Biol. Chem. 265:14292.
-
Jenne, D.E. et al. (1991) J. Biol. Chem. 266:11030.
-
Kounnas, M.Z. et al. (1995) J. Biol. Chem. 270:13070.
-
Pucci, S. et al. (2004) Oncogene 23:2298.
-
Moretti, R. M. et al. (2007) Cancer Res. 67:10325.
-
Santilli, G. et al. (2003) J. Biol. Chem. 278:38214.
-
Trougakos, I.P. et al. (2004) Cancer Res. 64:1834.
Alternate Names
Gene Symbol
UniProt
Additional Clusterin Products
Product Documents for Human Clusterin Antibody
Product Specific Notices for Human Clusterin Antibody
For research use only